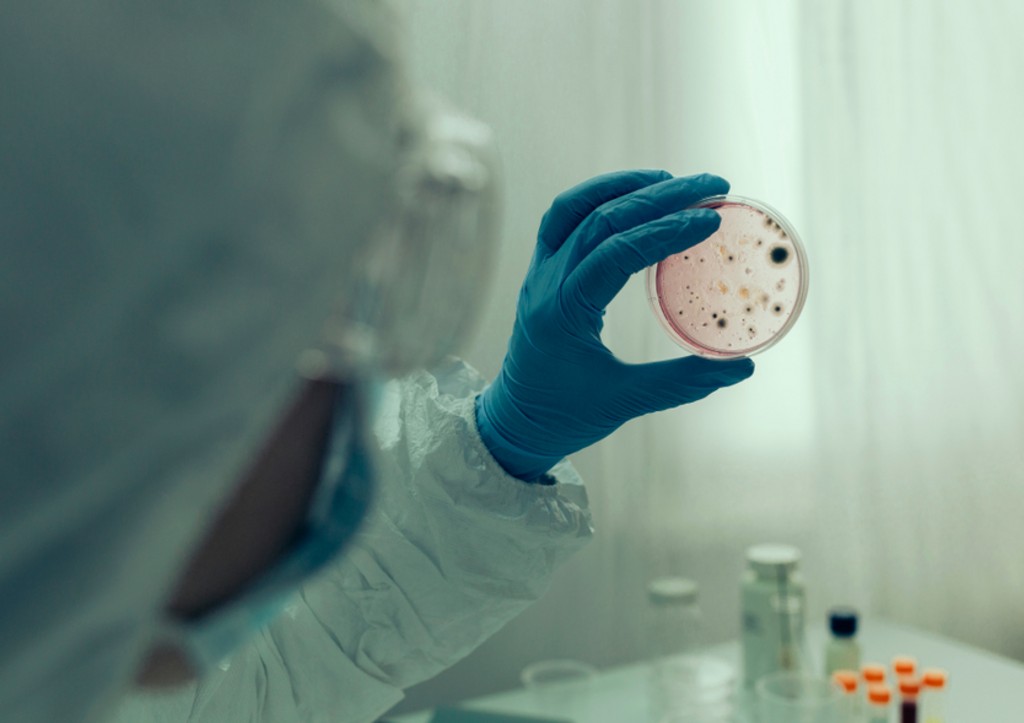
К Москве подбирается холера: кто распространитесь, уровень опасности

В Подмосковье зафиксирован случай холеры у туриста, прибывшего из Индии. Эксперты Роспотребнадзора оперативно выявили более 300 человек, контактировавших с заболевшим. Благодаря слаженным действиям специалистов все они находятся под медицинским наблюдением, что снижает риски распространения инфекции. Узнаем, как удалось взять ситуацию под контроль и какие меры гарантируют безопасность горожан.
Пациент с холерой: история заражения
40-летний мужчина вернулся в Московскую область из поездки по Индии и Непалу 21 апреля 2025 года. После появления симптомов недомогания он обратился за медицинской помощью и был госпитализирован. В рамках отпуска турист посещал местные кафе и употреблял фильтрованную воду, что, вероятно, стало причиной инфицирования.
«Благодаря оперативным действиям сотрудников Роспотребнадзора установлен круг контактных лиц в 33 регионах страны. Все они, включая членов семьи, пассажиров рейса и медиков, находятся под наблюдением», — отметили в ведомстве.
Механизм передачи инфекции: комментарии экспертов
По словам врача-терапевта Андрея Звонкова, холера распространяется фекально-оральным путем. Возбудители болезни могут попасть в организм через немытые руки, поверхности или пищу. «Даже кратковременный контакт с зараженным предметом представляет риск. Поэтому все потенциально инфицированные размещены в изоляторах до завершения инкубационного периода», — пояснил специалист.
Звонков подчеркнул: соблюдение санитарных норм и своевременная изоляция носителей минимизируют угрозу эпидемии. Решительные меры Роспотребнадзора уже доказали свою эффективность.
Прогнозы и профилактика
Несмотря на единичный случай, система здравоохранения демонстрирует готовность к подобным вызовам. Введение карантинных мероприятий и постоянный мониторинг контактных лиц позволяют с уверенностью говорить о контроле над ситуацией. Жителям Москвы и области рекомендуется соблюдать базовые правила гигиены, а туристам — тщательно подходить к выбору пищи и воды во время поездок.
Холера — это острая кишечная инфекция, о которой рассказал врач Андрей Звонков. Специалист обратил внимание, что главная опасность заболевания связана с быстрым обезвоживанием организма из-за интенсивной диареи. Однако при своевременной медицинской помощи риски тяжелых последствий сводятся к минимуму!
Почему сегодня холера менее опасна
Как пояснил эксперт, два десятилетия назад холера перестала считаться «особо опасной» инфекцией. Современная медицина успешно справляется с болезнью благодаря специальным регидратационным растворам и антибиотикам. «Сегодня холера поддается лечению, а летальный исход возможен лишь в случае полного отсутствия помощи», — подчеркнул Звонков.
Опасна ли эпидемия для России
Врач-эпидемиолог Геннадий Онищенко выразил уверенность: резких вспышек холеры в стране не предвидится. По его словам, система эпидемиологического контроля работает эффективно. Например, всех пассажиров рейса из Индии, где был зафиксирован случай заболевания, оперативно нашли и взяли под медицинское наблюдение. «Это отличный пример нашей готовности к таким ситуациям», — добавил специалист.
Россия ведет постоянный мониторинг холерного вибриона, унаследовав ещё с советских лет детальную систему оценки рисков. Наибольшая активность бактерии наблюдается в теплых регионах, таких как Краснодарский край и Крым, а также в странах Юго-Восточной Азии. В столице, несмотря на редкие находки холеры в сточных водах, система контроля остается на высоте. «Если бы вибрион не обнаруживали, это говорило бы о плохой работе служб», — с оптимизмом отметил Онищенко.
Как защищают здоровье граждан
Сезон кишечных инфекций традиционно начинается летом, и с 1970-х годов во всех регионах страны действуют контрольные точки забора проб воды. Как только её температура превышает 17°C, стартуют регулярные проверки. В этом году мониторинг уже начался: пробы берут в Москве, Подмосковье, Сибири и на Дальнем Востоке. К августу, когда холерный вибрион теряет активность, риск распространения инфекции снижается.
Читайте также:
«Скажи, где живет»: Онищенко развеял слухи о новом вирусе
Раскрыто, грозит ли миру новая пандемия в 2025 году
Фото: Shutterstock/FOTODOM
Будущее под защитой: как сохранить здоровье в сезон простуд
Эксперты в области иммунологии уверены: человечество способно эффективно противостоять вызовам времени. Сегодня мы имеем все инструменты, чтобы укреплять защитные силы организма и создавать надёжный щит против сезонных заболеваний.
Профилактика вместо тревог: рекомендации специалистов
Врачи напоминают: регулярное мытьё рук, сбалансированное питание и физическая активность остаются главными союзниками в борьбе с ОРВИ. Вирусологи также отмечают, что риски завоза новых штаммов минимальны благодаря современным методам эпидемиологического контроля. Важно сохранять бдительность, но не забывать — наука активно развивается, а мировая медицина объединяет усилия для защиты здоровья людей.
Специалисты призывают воспринимать заботу о себе как инвестицию в яркое будущее. Каждое простое действие — от проветривания комнаты до сезонной вакцинации — становится ступенькой к сохранению качества жизни и новых достижений!
Источник: news.ru






